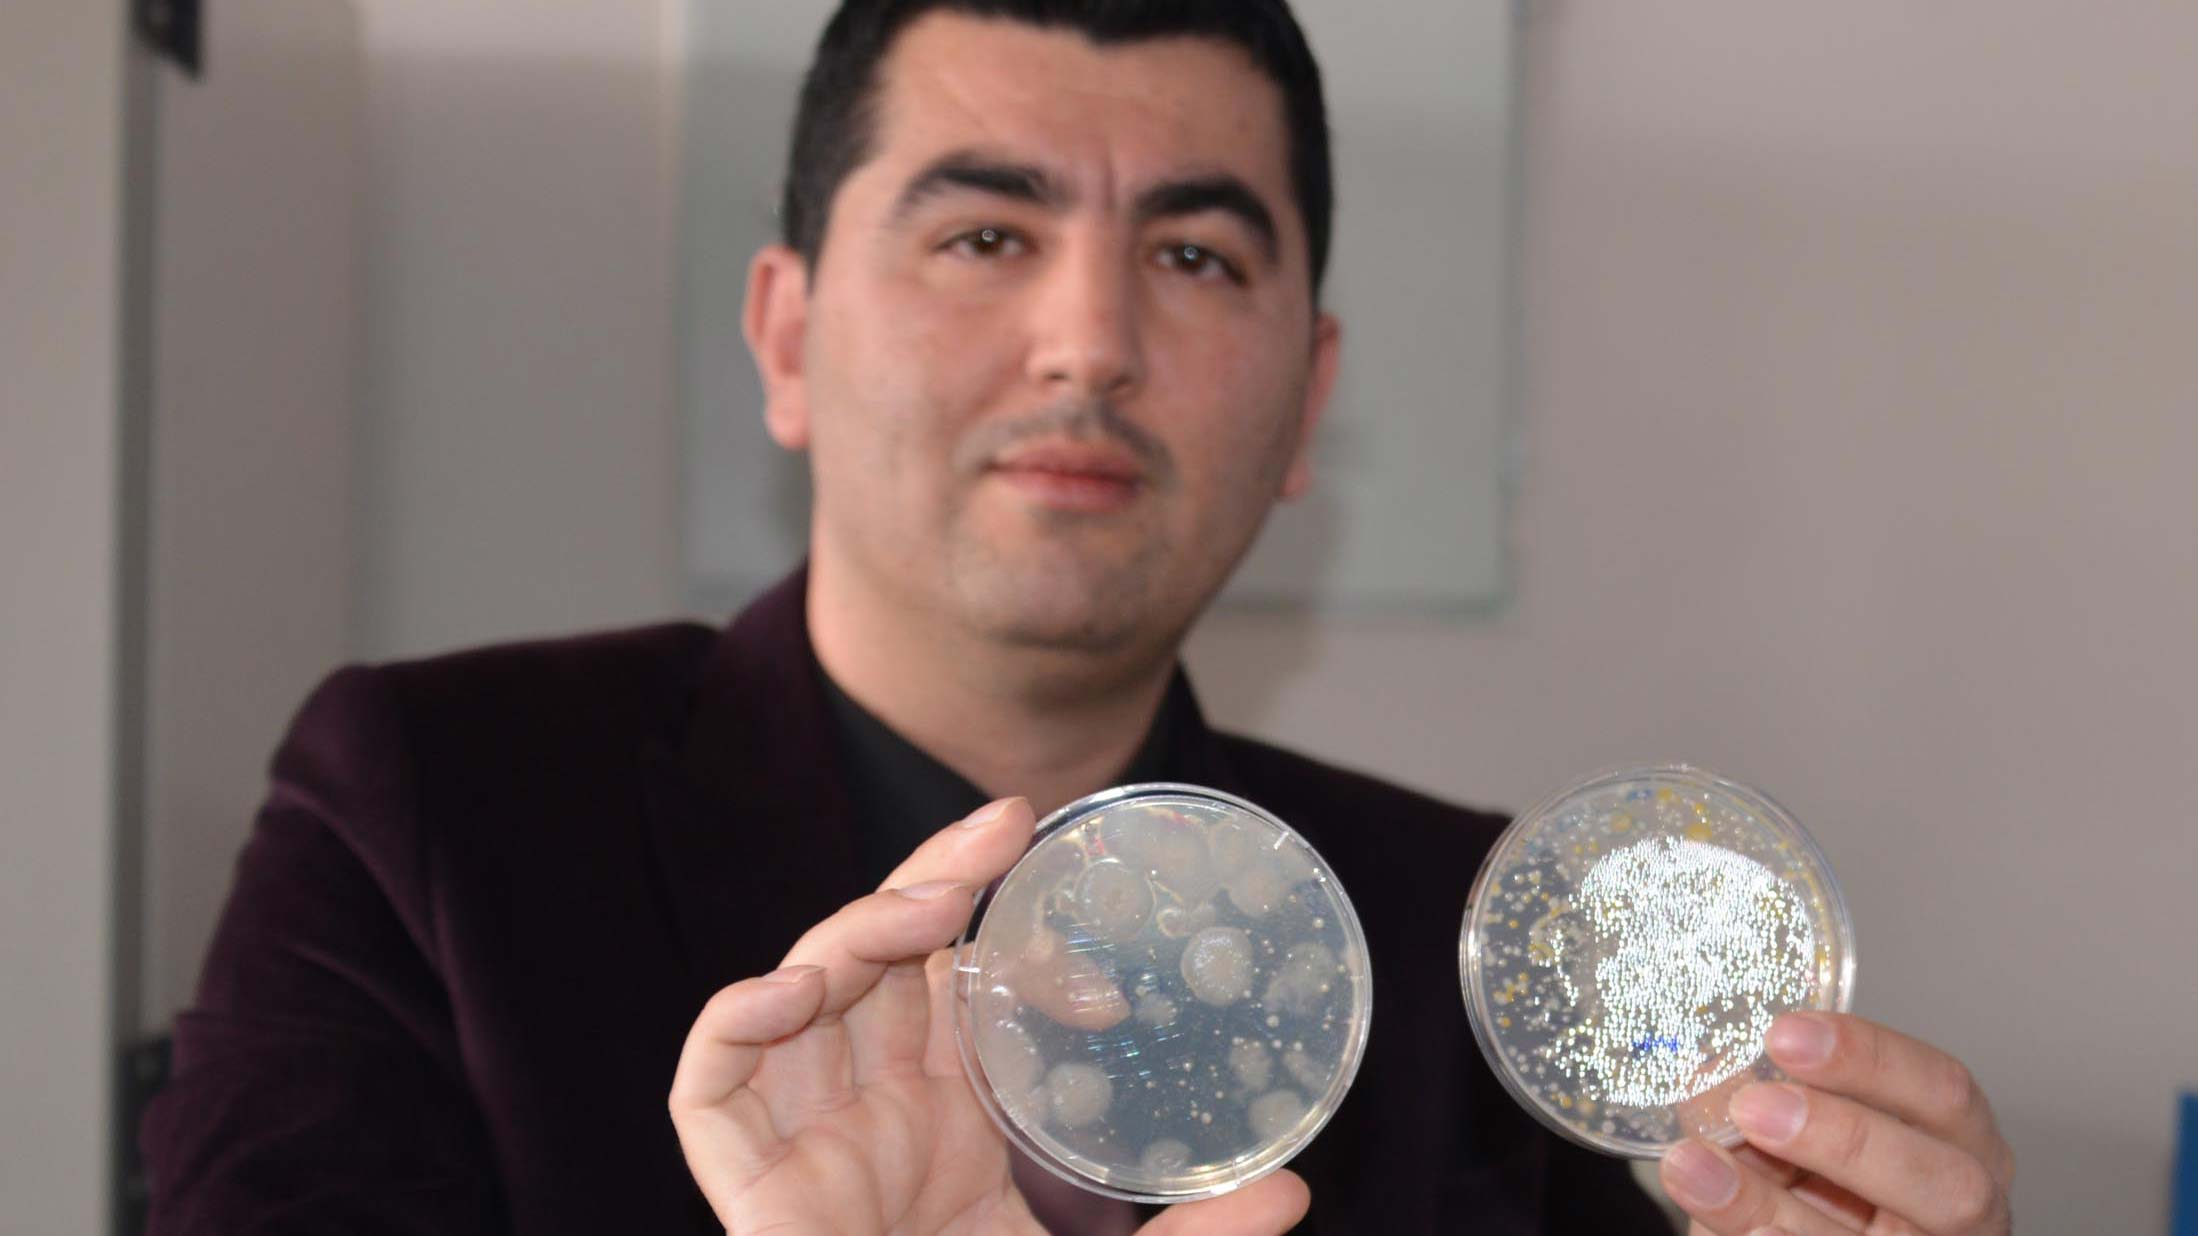

TÜBİTAK Marmara Araştırma Merkezi Kutup Araştırmaları Enstitüsü koordinasyonunda gerçekleştirilen 6’ncı Ulusal Antarktika’dan getirilen numunelerin mikrobiyal çeşitliliğini Erzurum’da kültüre almayı başardıklarını bildirdi.
Cumhurbaşkanlığı himayelerinde, Sanayi ve Teknoloji Bakanlığı uhdesinde, TÜBİTAK MAM Kutup Araştırmaları Enstitüsü koordinasyonunda gerçekleştirilen 6’ncı Ulusal Antarktika Bilim Seferine katılan Atatürk Üniversitesi Fen Fakültesi Biyoloji Bölümü Dr. Öğretim Üyesi Mehmet Karadayı ile Astrofizik Araştırma ve Uygulama Merkezi (ATASAM) Teknik Müdür Yardımcısı Dr. Onur Şatır, Erzurum’a döndü. 22 Ocak’ta başlayan ve 46 gün süren Antarktika seferinde Karadayı ve Şatır Türk üssünün bulunduğu Horseshoe Adası’nda çalışma yaptı.

‘ANTARKTİKA EL DEĞMEMİŞ MADEN’
Antarktika’nın ve Türk üssünün bulunduğu adanın biyoçeşitlilik çalışmaları için el değmemiş maden olduğunu belirten Fen Fakültesi Biyoloji Bölümü Dr. Öğretim Üyesi Mehmet Karadayı, çok sayıda kıymetli numune getirme şansı elde ettiğini söyledi. Antarktika’da yaptığı çalışmalardan elde ettikleri numuneler üzerinde çalışmalara başladıklarını belirten Karadayı, “Yerli ve milli teknolojiler geliştirecek, enzim sanayine katkı sağlayacak mikrobiyal kültürleri laboratuvarlarda geliştirmeye çalışıyoruz. Bugün getirdiğimiz numuneler konusunda sevindirici bir gelişme oldu.
Getirdiğimiz çok sayıda numunenin mikrobiyal çeşitliliğini Erzurum’da kültüre almayı (geliştirmeyi) başarmış bulunmaktayız. İleriki çalışmalarda bunları biyoteknolojik açıdan değerlendirmeyi planlıyoruz. Yeni türlerin ortaya çıkması, ülkemizin uluslararası bilimsem camiada temsili için oldukça önemli. Aynı zamanda biz sadece bilimsel veri üretmekten ziyade buradan ülke ekonomisine katkı sağlayacak teknolojiler geliştirmeyi hedefliyoruz. Bu noktada soğuğa adapte enzim üreten organizmaları geliştirip, yerli ve milli bir teknoloji haline dönüştürerek ülke ekonomisine katkı sağlamayı amaçlıyoruz. Şu an oradaki organizmaları canlı olarak laboratuvarımızda geliştirmeyi başardık.

Bu noktada çalışmamızın kaynağı olan Antarktika’ya ihtiyacımız kalmadı. Bu enzimleri üretmeyi başarabilirsek dışardan dövizle satın aldığımız enzim katkılarını ülkemizde üretip kendi teknolojimizi geliştirebiliriz” diye konuştu.
‘TELESKOP İÇİN ÖLÇÜMLER YAPTIK’
Atatürk Üniversitesi’nden hazırladıkları projeyle Antarktika seferine katıldığını belirten ATASAM Teknik Müdür Yardımcısı Dr. Onur Şatır, “Projemizin kapsamı, ülkemizin ileride Antarktika kıtasında kurmayı planladığı kutup teleskobunun bir ön çalışmasını yapmaktı. Şu an üssümüzün bulunduğu yerin astronomik anlamda kalitesinin ölçülmesi üzerineydi. Bu anlamda iki aland6a ölçümler aldık. Biri kozmik ışınlar üzerineydi diğeri de atmosferik kalite, gök kalitesi, gökyüzünün karanlığı ve bulutluluk üzerineydi. Orada olduğumuz sürece ölçümlerimizi başarıyla yaptık” dedi.
ATASAM olarak Erzurum’da Doğu Anadolu Gözlemevi (DAG) projesini yürüttüklerini hatırlatan Şatır, şunları söyledi:
“Erzurum’da Karakaya Tepeleri’nde 3170 metre rakımda. Aslına bakarsanız Antarktika şartlarına çok benzer şartlarda bir teleskop kuruyoruz. Astronomlar olarak bizim istediğimiz üzerimizdeki gökyüzünün bizim gözlemlerimizi olabildiğince az etkilemesi. Olabildiğince soğuk, sakin ve nemsiz bir hava. Erzurum’da gözlemevi yerleşkesinde biz buna sahibiz. Antarktika’da da aslına bakarsanız astronomlar için dünyanın en iyi yerlerinden biri. Anakaranın merkezlerinde 4000 metre üzerinde rakıma sahip platolar var. Buralarda atmosfer çok kuru, nem yüzde 1-2’lerde. Çok durgun, soğuk aynı zamanda kutupta olması sebebiyle de kışın geceler çok uzun. Hatta birkaç ay güneşin doğmadığı dönemler var. O yüzden astronomi için orası dünyanın en iyi yerlerinden biri. ,
Türk üssünün bulunduğu Horseshoe Adası, Antarktika kıtasının sahilinde. Oranın astronomik olarak kalitesinin merkezle ne kadar benzediğini ölçmek için yaptığımız bir projeydi. Gördük ki yine iyi şartlara sahip ama kıta merkezi kadar olmasa da haliyle daha ufak çaplı bir teleskobun kurulması için uygun bir yer. Ama dediğim gibi dünya standartlarında bir gözlem yapmak için gidilmesi gereken yer Antarktika’nın merkezindeki yüksek platolar”











